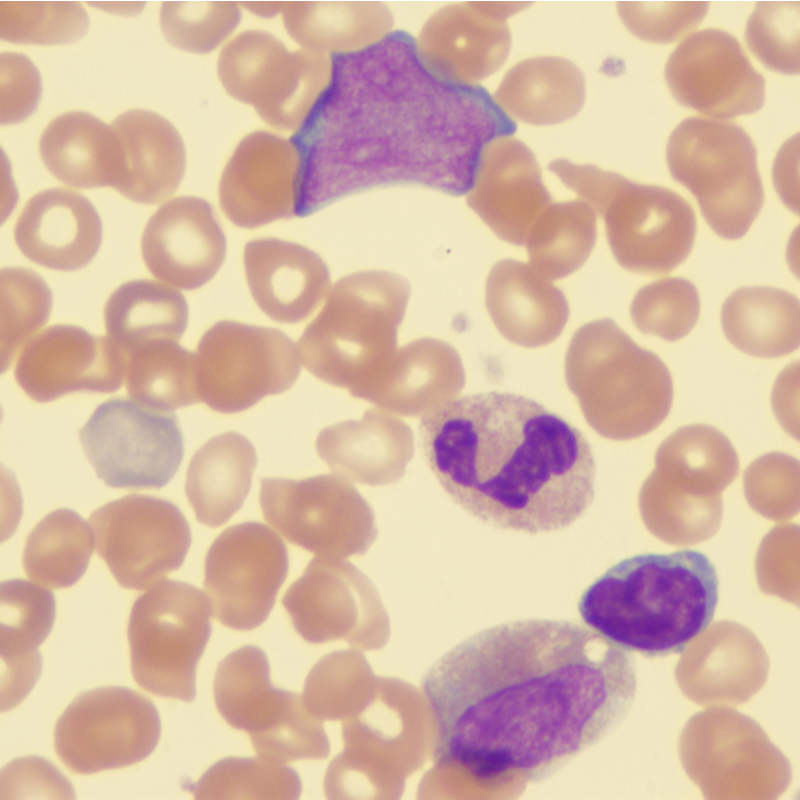
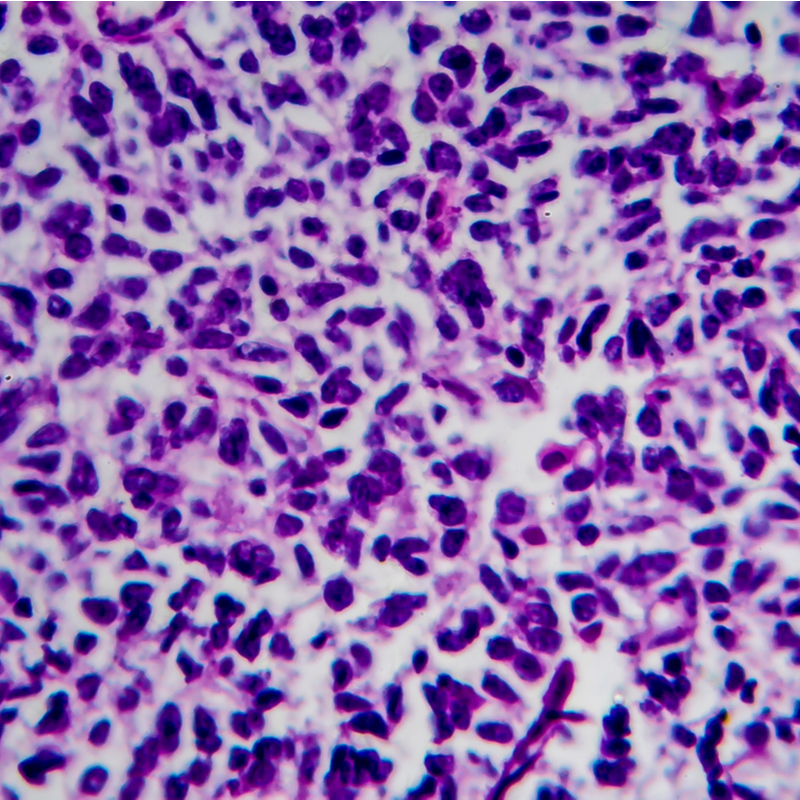

- Frekvenču sistēmas
-
Blogs
- Labdabīgi audzēji (labdabīgi)
- Audzējs ļaundabīgs (ļaundabīgs)
- Polipi
- Cistas
- Vīrusi
- Baktērijas
- Dermatoloģija un frekvences
- Ginekoloģija un frekvences
- Slimības un biežums
- Neoplāzija un frekvences terapija
- Patogēni un frekvences terapija
- Ezotērika un frekvenču terapija
- Ūdeņradis - frekvenču terapija
- Tēmas Elektrosmogs
- KE garšaugu blogs
- Frekvences terapijas pamats
- Biozapper
- Mednieks 4025 - Meta mednieks
- Frekvenču terapija Austrijā
- Veselība kopumā
- Elementu teorija
- Mikoterapija
- Vitāli svarīgs lauks
- Alerģijas
- Skābes un bāzu līdzsvars
- Sēnīšu slimības
- Grāmatu ieteikumi
- Papildterapija
- Papildinājumi
- E-smog
- Frekvences
- Analīze
- Akadēmija
Krebs und begleitende Frequenztherapie
Krebs ist eine Krankheit, die weltweit Millionen von Menschen betrifft und deren Auswirkungen verheerend sein können. Die Diagnose Krebs kann ein Schock sein und stellt sowohl für Betroffene als auch für ihre Angehörigen eine enorme körperliche, emotionale und finanzielle Belastung dar. Während die konventionelle Krebstherapie in Form von Operation, Bestrahlung und Chemotherapie oft als Standardbehandlung angesehen wird, suchen immer mehr Menschen nach alternativen Behandlungsmethoden, um ihre Heilungschancen zu verbessern und die Nebenwirkungen der herkömmlichen Therapien zu reduzieren. Eine vielversprechende Option, die immer mehr an Bedeutung gewinnt, ist die begleitende Frequenztherapie.
Die Idee der Frequenztherapie basiert auf der Annahme, dass jede Zelle und jedes Organ im Körper eine eigene Schwingung oder Frequenz hat. Bei einer Krankheit wie Krebs ist diese Frequenz gestört, was zu einer Fehlfunktion der Zellen führt. Die begleitende Frequenztherapie versucht, diese gestörten Frequenzen mithilfe von elektrischen Impulsen oder elektromagnetischen Wellen auszugleichen und somit die Selbstheilungskräfte des Körpers zu aktivieren.
Die Anwendung von Frequenztherapie in der Krebstherapie ist nicht neu. Schon in den 1920er Jahren experimentierte der Arzt Royal Rife mit elektrischen Frequenzen, um Tumorzellen zu zerstören. In den letzten Jahren hat die Forschung in diesem Bereich jedoch erhebliche Fortschritte gemacht und immer mehr Studien belegen die Wirksamkeit der begleitenden Frequenztherapie bei der Behandlung von Krebs.
Ļaundabīgi audzēji un frekvenču terapija

Onkoviren, Bakterien und Parasiten: Wie Mikroorganismen Krebs beeinflussen – und welche Rolle Frequenztherapie spielen könnte

Vēzis un frekvenču terapija: cerība, zinātne un nākotnes perspektīvas

Pretvēža diēta

Dr. Royal Rife un frekvenču terapija saistībā ar vēzi

B šūnu limfoma

Bovena slimība

Burkita limfoma

CUP sindroms

Epitēlija ļaundabīga

Fibrosarkoma

Glioblastoma

Gorlina sindroms

Horeoidālā melanoma

Jvinga sarkoma

Kakla audzējs

Kaposi sarkoma

Krukenberga audzējs

Krūškurvja sienas audzējs

Kuņģa un zarnu trakta stromālais audzējs

Liposarkoma

Morvana sindroms

Ne-Hodžkina limfoma

Oligoastrocitoma

Oligodendroglioma

Osteosarkoma

Rabdomiosarkoma

Smadzeņu audzējs

Vilmsa audzējs

Audzēji - Ortodoksālā medicīna - Papildterapija

Audzēju cēloņi

Audzēju procesu profilakse

Kā attīstās vēža šūnas?

Ļaundabīgas meningiomas

Sarkomas un frekvences terapija

Ādas vēzis

Aizkuņģa dziedzera vēzis

Aknu karcinoma

Anal karcinoma

Ausu vēzis

Balsenes karcinoma - balsenes vēzis

Balts ādas vēzis

Barības vada vēzis

Bazālo šūnu karcinoma

Bronhiālā karcinoma

Deguna vēzis

Dzemdes kakla vēzis

Dzemdes vēzis

Dzimumlocekļa vēzis

Endometrija karcinoma

Holangiokarcinoma - Žultsceļu karcinoma

Kā attīstās vēža šūnas?

Karcinoīds

Kaulu vēzis

Kolorektālais vēzis

Krūts vēzis (krūts karcinoma)

Kuņģa vēzis

Mēles karcinoma

Melnais ādas vēzis

Merkeļa šūnu karcinoma

Mutes dobuma plakanšūnu karcinoma

Nazofaringeālā karcinoma

Nieru šūnu vēzis

Olnīcu vēzis

Orofaringeālā plakanšūnu karcinoma

Prostatas vēzis

Rīkles karcinoma

Sēklinieku vēzis

Siekalu dziedzeru vēzis

Tonsilu vēzis

Urahu karcinoma

Urīnpūšļa karcinoma

Vairogdziedzera vēzis

Vairogdziedzera vēzis

Virsnieru garozas vēzis

Vulvas karcinoma

Žultspūšļa karcinoma

Arahnoīdā sarkoma

Bazālo šūnu nevus sindroms

Hipofaringeālā karcinoma

Izolīšu šūnu karcinoma

Ļaundabīgas meningiomas

Ļaundabīgs smadzeņu audzējs

Lentigo maligna

Merkeļa šūnu karcinoma

Miksoīdā epitēlioīdā sarkoma

Multiplā mieloma

Mycosis fungoides

Neuroblastoma

Pageta slimība

Paraganglioma

Plazmocitoma

Retinoblastoma

Sezārija sindroms

Siekalu dziedzeru vēzis

T-šūnu limfoma

Timiskā karcinoma

Valdenstrēma makroglobulinēmija

Zollingera-Elisona sindroms

Dzimumšūnu audzējs vīriešiem

Medulloblastoma
Mielofibroze
Nefroblastoma








